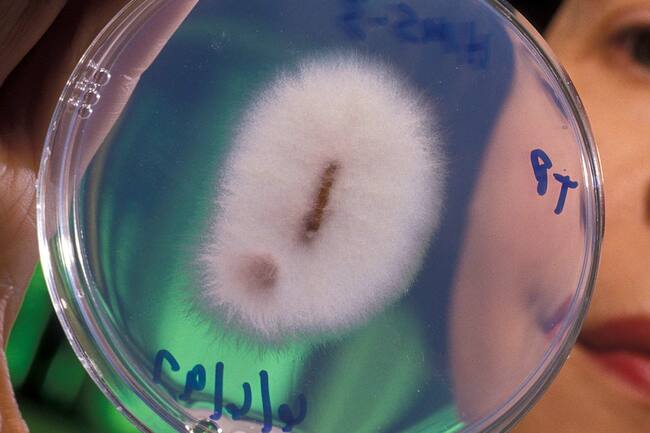
What's Eating You? 5 Fascinating Facts About Parasites

2023-08-22 18:32
What's Eating You? 5 Fascinating Facts About Parasites
The definition, Gibson said, often depends on who the host is and which scientist you're asking. Gibson recently discussed five wild facts about parasites with UVA Today. 1. Parasitism is the most common survival strategy in the world. In terms of body count, beetles constitute about a quarter of the 7.7 million known species on our planet, about half of which are themselves parasitic. "There's this famous quote by evolutionary biologist J.B.S. Haldane saying, 'It would appear that God has an inordinate fondness for stars and beetles,'" Gibson said.
https://www.miragenews.com/whats-eating-you-5-fascinating-facts-about-1069895/
#miragenews
https://www.miragenews.com/whats-eating-you-5-fascinating-facts-about-1069895/
#miragenews
You must login before you can post a comment.